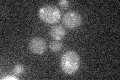

View description
Probable Hsp40p co-chaperone, has a DnaJ-like domain and appears to be involved in ER-associated degradation of misfolded proteins containing a tightly folded cytoplasmic domain; inhibits replication of Brome mosaic virus in S. cerevisiae
Localization:
Intensity:
Fold change:
Significance:
-
C’ GFP library in SD

below threshold16.62 -
N' NOP1pr-GFP in SD

below threshold17.5162 -
N' TEF2pr-mCherry in SD

missing0 -
N' NATIVEpr-GFP in SD

missing0 -
N' TEF2pr-VC and Cyto-VN in SD

#N/A0 -
C’ GFP library in SD+DTT

cytosol16.580.99No -
C’ GFP library in SD+H2O2

cytosol18.111.08No -
C’ GFP library in Starvation Media
cytosol16.921.01No -
C’ GFP library on the background of Pup2-DaMP

below threshold -
C’ GFP library on the background of CCT mutant

below threshold17.13631.03104No
